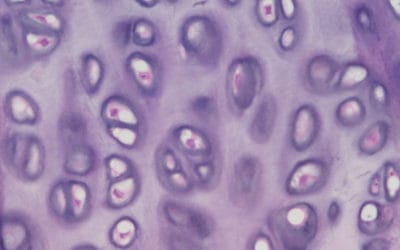
Connective tissue disorders and pelvic floor muscle dysfunction: Is there a connection? Part I

As Thanksgiving beckons, we wanted to send you off into the holiday weekend with some enlightening fun. Here, from...
Blog
We Go Above and Beyond the Basics
category  
(More) Kegels for Men?!
By Riva Preil Women have long been familiar with the benefits of pelvic floor strengthening exercises, colloquially...
Detox the Box!
Women's Voices for the Earth is an organization seeking to eliminate toxic chemicals from female health products. They...
Irritant Information
By Riva Preil On June 9, we posted a fantastic YouTube video on our website entitled “Detox the Boxâ€, a parody on a...
A New Vagina?
By Riva Preil Illustration by Ly Ngo, courtesy of Refinery 29 On rare occasion, I have heard patients comment...
Is It All In My Head?
By Riva Preil Join us tonight at Beyond Basics, 7:00 PM, for the next installment of The School of Pelvic Health. The...
Connective tissue disorders and pelvic floor muscle dysfunction: Is there a connection? Part I
By Stephanie Stamas, SPT Connective tissue disorders (CTD) cause dysfunction in the structures that support, bind, and...
Never Too Soon
1436
Ob/Gyns Can Treat Men Again!
1547